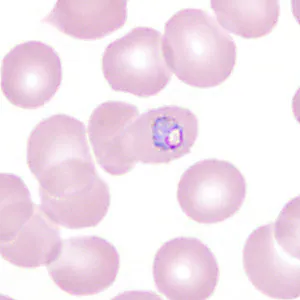
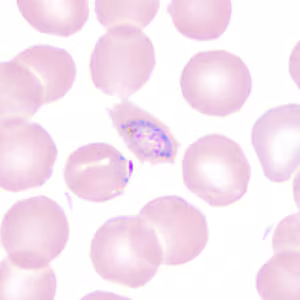
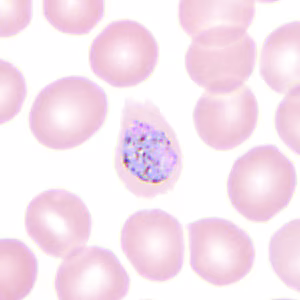

Case #350 – June, 2013
A 45-year-old man with travel history to Ghana presented to his health care provider with recurrent fever and chills. He admitted to not taking any kind of malaria prophylaxis during his travels. Blood smears were prepared, stained with Wright’s stain, and examined. The laboratory initially reported Plasmodium falciparum but requested confirmation from a reference laboratory, so the slides and EDTA blood were sent to the CDC-DPDx for diagnostic assistance. Figures A–I show what was found on one of the stained thin smears. What is your diagnosis? Based on what criteria? What, if any, other tests would you recommend?

Figure A

Figure B

Figure C
Figure D

Figure E

Figure F
Figure G

Figure H
Figure I
Images presented in the DPDx case studies are from specimens submitted for diagnosis or archiving. On rare occasions, clinical histories given may be partly fictitious.
DPDx is an educational resource designed for health professionals and laboratory scientists. For an overview including prevention, control, and treatment visit www.cdc.gov/parasites/.
